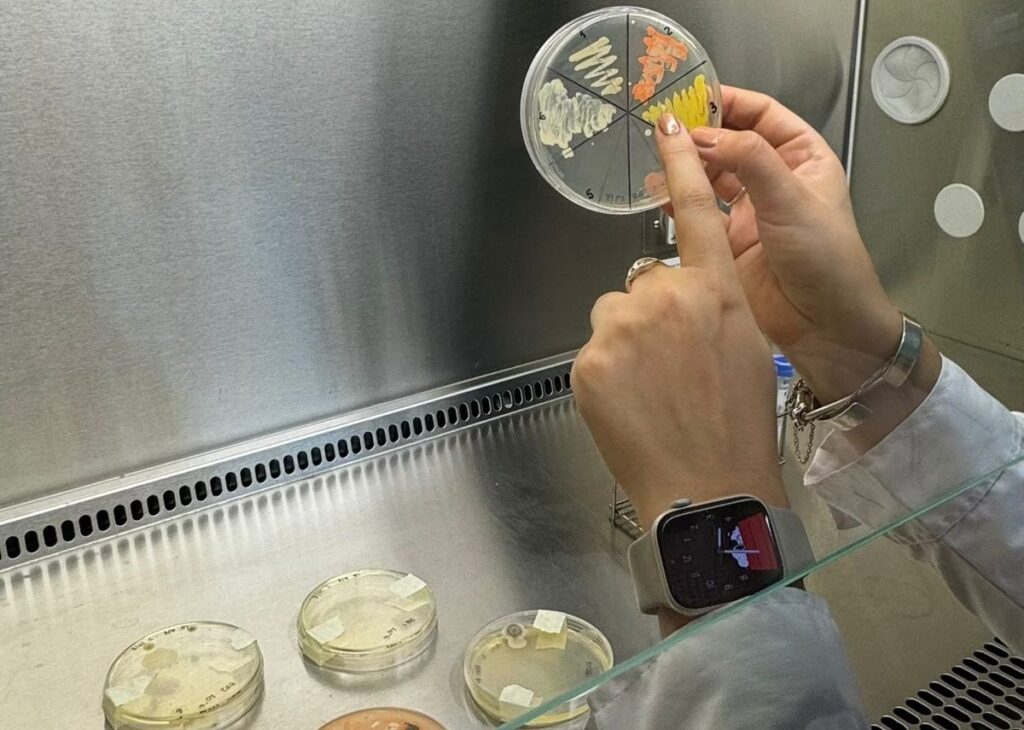

Un equipo multidisciplinario de la Universidad Nacional del Noroeste de la Provincia de Buenos Aires (UNNOBA), busca elaborar un kit de enzimas y bacterias para remediar suelos contaminados a causa de la explotación masiva por la producción agropecuaria o como consecuencia de la actividad industrial.
Se trata de una nueva línea de investigación del Departamento de Ciencias Básicas y Experimentales de esa casa de estudios -financiada a través de la convocatoria Ideas-Proyecto de la Comisión de Investigaciones Científicas- que tiene el objetivo de aislar y caracterizar bacterias autóctonas de sitios contaminados para identificar aquellas que puedan ser utilizadas en la biorremediación de esos suelos.
El estudio parte de diagnosticar la situación de zonas del noroeste provincial en las que los suelos se ven afectados sobre todo por la actividad intensiva de producción agropecuaria. El uso de agroquímicos sumado a la falta de rotación de los suelos genera un agotamiento tal que impiden la capacidad propia de la naturaleza para reparar ese nivel de contaminación.
Pero existen microorganismos que tienen capacidad biorremediadora y si son identificados podrían ser utilizados para revertir la situación. “Hay grupos de bacterias del género Pseudomonas y Bacillus que tienen en su genética, a lo largo de la evolución, herramientas para convertir compuestos que son contaminantes para el medioambiente en otros que pueden ser utilizados como materia orgánica y volver al ciclo de la cadena trófica, es decir, regresar esa energía a la cadena productiva”, explica la Dra. María José Torres, directora del proyecto.

La intención del estudio es identificar esas cepas bacterianas y desarrollar soluciones tecnológicas sostenibles y económicas para la recuperación de sitios contaminados, principalmente en las ciudades de Junín y Pergamino (donde se encuentran las sedes de la UNNOBA), aunque los resultados podrían ser extensibles a otros municipios del noroeste provincial.
Para lograr esto, conformaron un equipo multidisciplinario en el que intervienen profesionales de la biología, bioquímica, biotecnología, ingeniería agronómica y estudiantes de genética que se encuentran haciendo sus tesis de licenciatura.
Un cóctel natural
El trabajo del equipo de investigación consiste en tomar muestras de suelos presuntamente contaminados de las mencionadas ciudades, no sólo de sitios afectados por la actividad agropecuaria sino también por la industrial y luego realizar análisis metagenómicos para buscar microorganismos de interés para la biorremediación.
“La idea no es sólo identificar estas bacterias con capacidad biorremediadora y poder aislarlas, sino también purificar las enzimas de estas bacterias, que serían las ‘fábricas’ que están en su interior y que son las encargadas de esta transformación. Esto lo hacemos pensando en elaborar un cóctel que en el futuro se pueda comercializar como producto”, explicó la Dra. Leticia Baccarini.
En ese sentido, Torres remarca: “estas son tecnologías que están dando los primeros pasos, las cuales llevan mucho trabajo y estudio. Podemos tener un pantallazo de lo que sucede a baja escala y en un sector determinado, pero siempre se busca que esas condiciones puedan replicarse en otros sectores con el mismo tipo de contaminación. Nuestra idea es hacerlo a través de un cóctel, presentado como un kit con determinadas cantidades o concentraciones de enzimas y bacterias necesarias para tratar el residuo de manera natural. Esa sería la llegada directa al público demandante”.
Inteligencia artificial
El proceso de investigación ya tuvo sus avances: las bacterias están aisladas y caracterizadas. Ahora el trabajo está centrado en armar lo que denominan “consorcios” o grupos de microorganismos que en conjunto puedan remediar los suelos contaminados. Para acelerar ese proceso, utilizarán inteligencia artificial.
“Estamos entrenando a una inteligencia artificial con bibliografías y bases de datos específicas que hablen de biorremediación, enzimas y bacterias, para que nos ayude a armar esos consorcios o grupos que sean compatibles entre sí y que tengan potencial biorremediador en base a toda la caracterización que hicimos”, desarrolla la Dra. Fiorella Spinelli y aclara: “por supuesto que esto después hay que validarlo”.
“Muchos de los resultados obtenidos en el laboratorio sobre las características bioquímicas de esas bacterias ya se utilizan para entrenar a esa inteligencia artificial, y poder acelerar la limitante propia que tiene la biorremediación que es el tiempo. Hacer todo un trabajo de investigación teórica, se capitaliza al entrenar este algoritmo y poder ayudarnos a decidir qué cóctel sería el más beneficioso para algún tipo específico de contaminante”, agrega Baccarini.
El objetivo es que tras el entrenamiento las investigadoras puedan preguntarle a la plataforma virtual sobre un contaminante o un grupo de contaminantes y ésta responda con qué bacterias o grupos de enzimas se puede tratar.
El enfoque desde el que trabaja el equipo de la UNNOBA parte de aprovechar los recursos naturales existentes en la zona para desarrollar soluciones que permitan reducir el impacto ambiental de la actividad productiva en la región. “La importancia de la caracterización de bacterias autóctonas radica en que ellas reflejan las condiciones de su hábitat y mantienen el nicho ecológico”, afirman.
Por David Barresi